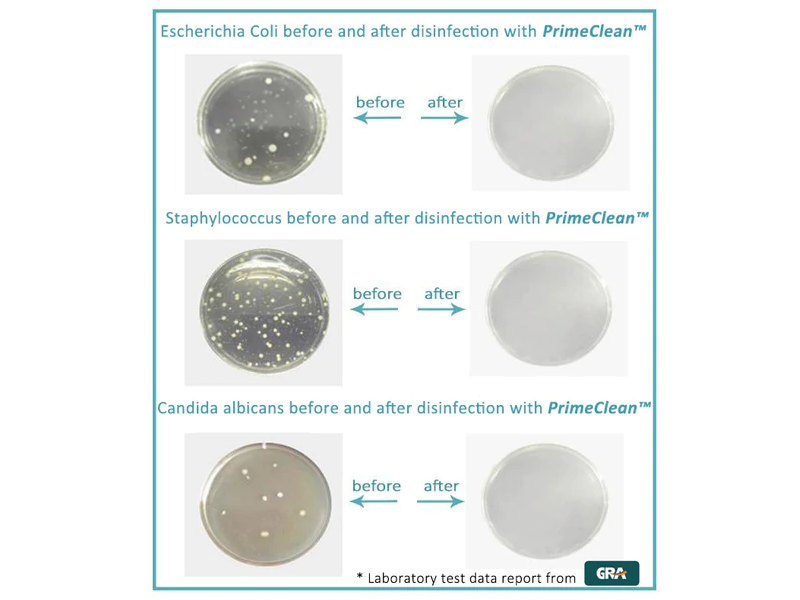

Bacteria, Fungi, Viruses – Know Your Enemy
June 10, 2022 by Prime Clean
We already mentioned numerous times the risk of using dirty CPAP equipment… If you are already a CPAP user, you know by now that sanitizing and cleaning your CPAP is a daily activity and that not doing it can create serious health complications and make you sick. But what’s the exact thing that is causing those health issues? Why is it necessary to sanitize daily? Take a few minutes of your time to read this article and learn more about mold, bacteria, fungi, and viruses…
CPAP Equipment
Continuous Positive Airway Pressure (CPAP) therapy was developed by Dr. Colin Sullivan in 1980. As a treatment for sleep apnea disorder. Ever since then it has proven to be overall the best solution for obstructive sleep apnea (OSA). An essential part of CPAP therapy is the CPAP machine. Dr. Sullivan developed the same-named (CPAP) machine as a solution to OSA issues and till today the main design and the way the machine works haven't changed much. As the name continuous positive airways pressure suggests, the CPAP machine uses continuous airflow pressure pushed into the user’s upper airways to keep them opened i.e. unobstructed. Although besides CPAP there are two technically more advanced machines (APAP (automatic positive airway pressure) and BiPAP (bi-level positive airway pressure), CPAP device is the most common PAP machine used in sleep apnea therapy; it is a simple, highly efficient, budget-friendly.
Today’s top CPAP manufacturers are ResMed (directly linked to Dr. Colin Sullivan’s ResCare Limited), Phillips Respironics (currently the world’s biggest manufacturer), Somnetics, Fisher & Paykel, DeVilbiss…), and these companies are pushing the CPAP industry forward developing and improving it, and together with the CPAP accessories industry (CPAP Cleaning Supplies, CPAP sanitizers: CPAP Cleaning Machine, Ozone CPAP Cleaner, UV CPAP cleaners; hose management items, CPAP pillows, chine straps…), is helping an ever-growing number of diagnosed sleep apnea patients (the sleep apnea devices market is expected to reach $12.9 billion by 2027).
What part of the CPAP device needs to be cleaned and sanitized regularly? As mentioned before in one of our articles, every PAP machine contains 3 main parts: a motor/compressor (the machine itself), a hose, and a mask. Other parts are air filter(s), humidifier, mask straps, and tubing/hose connectors (some of the other parts might not be listed with all machines, but mostly it is the ones we mentioned). All parts need to be maintained and replaced according to the manufacturer's instructions. The parts that need to be cleaned and sanitized daily (or at least once a week!) are the parts that are in contact with a user the most often and are in contact with moist/water, CPAP mask, connectors, hose, and humidifier.
Bacteria, Fungi, Viruses
Collectively known as germs, bacteria, fungi, and viruses are microscopic organisms that live all around and inside us. As MedlinePlus (National Library of Medicine) states: Germs are microorganisms. This means that they can be seen only through a microscope. They can be found everywhere - in the air, soil, and water. There are also germs on your skin and in your body. Many germs live in and on our bodies without causing harm. Some even help us to stay healthy. But some germs can make you sick. Infectious diseases are diseases that are caused by germs. The main types of germs are bacteria, viruses, fungi, and parasites.
Bacteria. Bacteria are one-celled microorganisms that can be seen only using a microscope. Even though bacteria are most often associated with disease, not all bacteria are harmful; we even have some bacteria that live in our body and that are helpful (necessary) for our normal life and existence (for example, Lactobacillus acidophilus is a harmless bacterium that resides in our intestines and helps digest food, and even destroys some disease-causing organisms).
The “bad”, disease-causing, bacteria produce toxins which are chemicals that damage our cells and by doing so make us ill. Some more known bacterial infections are: strep throat, urinary infections, and Tuberculosis.
Bacteria are successfully treated with antibiotics (in most cases).
Viruses. Viruses are much smaller than bacteria and by that, much smaller than most of our cells. To put it simply, viruses are just capsules that contain genetic material. Viruses reproduce in a way that they invade our cells and take over the parts that make cells work normally. During this process, host cells are often eventually destroyed, and this is what makes us ill. The most common or recognizable diseases caused by viruses are: Common cold, Influenza, Measles, Chickenpox, AIDS, COVID-19…
As effective as the antibiotics are on the bacteria, on viruses they have no effect whatsoever. The only way we can with viruses is by boosting our immunity and letting our body's immune system handle it.
Fungi. Although we even enjoy eating some of them (mushrooms are fungi, the yeast used for making bread is fungi, and the mold used in some cheese as delicacy is also fungi), fungi can also be a microorganism that is extremely dangerous to our health. Take for example candida; Candida is yeast fungi that can cause an infection and serious health issues. In some small quantities, Candida is always present in our body; however, it is "activated" when our immunity is low (our lowered immune system cannot suppress the candida multiplying too much). Other more known fungi infections are skin diseases such as athlete's foot and ringworm.
How to Prevent Germs to Grow in Your CPAP Equipment?
We wrote before about the necessity of sanitizing your CPAP equipment; whether you are a new or experienced CPAP user, one of the main things you know is probably that you have to keep your equipment clean and sanitized. Germs love moist warm places and grow much faster in such environment. Your face mask or hose is an ideal breeding ground for germs…warm, moist air you are exhaling (or from a heated hose and humidifier). That is why sanitizing those parts of your CPAP equipment should be a daily activity.
Cleaning and sanitizing can be done in two ways: manually or automatically. Now, manual cleaning is a hustle…it takes 15-30 minutes of your time (if you want to do it properly), and then after washing and sanitizing you must make sure it is fully dried…it takes your time and it's a hustle (it can be somewhat faster and safer if you decide to use CPAP Cleaning Supplies such as wet wipes or similar). Automatic sanitizing using a CPAP Cleaning Machine, on the other hand, is a quick and simple way of handling that task; all you need to do is to put your CPAP equipment into sanitizing bag (container) and click the button to start the process. With Ozone CPAP Cleaner this process is (automatically) done in around 30 minutes. If you feel doubtful that there is a better way than manual cleaning, no need to doubt or worry, ozone sanitizer is extremely efficient! PrimeClean® CPAP Cleaner will kill 99.9% of germs within those 30 minutes…you won’t hear it work, you won’t feel anything, no heat, no unpleasant smell, it’s a dry process so after it’s finished no need to do anything.
The main features of Primeclean CPAP Cleaner are:
- Automatic Cleaning
- Kills 99.99% of germs and bacteria in only 30 minutes!
- Requires no soap, water, or cleaning solutions
- Small and portable, weighing only 8 ounces
- Ultra-quiet
- Uses Ozone (activated oxygen) to disinfect
- 10-year Battery life
- Charging time is only 2 hours
- Requires no maintenance
- Ideal for homecare, but can be used to clean multiple masks in a hospital setting
- 12-month warranty
As effective with sleep apnea disorder as CPAP is, deserves all the trust in it. However, if you don’t maintain your CPAP equipment properly and clean/sanitize it regularly, it can bring more harm than good!